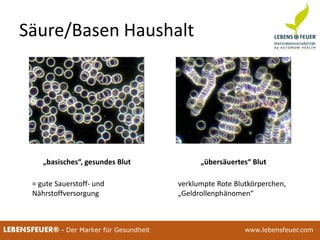
25.02.2015 9225.02.2015 92LEBENSFEUER® - Der Marker für Gesundheit www.lebensfeuer.com25.02.2015 92LEBENSFEUER® - Der Marker für Gesundheit www.lebensfeuer.com
Säure/Basen Haushalt
„basisches“, gesundes Blut
verklumpte Rote Blutkörperchen,
„Geldrollenphänomen“
= gute Sauerstoff- und
Nährstoffversorgung
„übersäuertes“ Blut

Das Dokument erläutert die Bedeutung der Herzratenvariabilität (HRV) im Sport, insbesondere ihre Rolle bei der Trainingssteuerung und der Erkennung individueller Anpassungsfähigkeiten von Athleten. HRV-Analysen bieten ein differenziertes Bild der physiologischen Reaktionen auf Training und Alltag, wodurch Athleten ihre Leistungsfähigkeiten besser verstehen und anpassen können. Zudem werden verschiedene Methoden zur HRV-Messung und deren Einfluss auf die Trainingsplanung diskutiert.